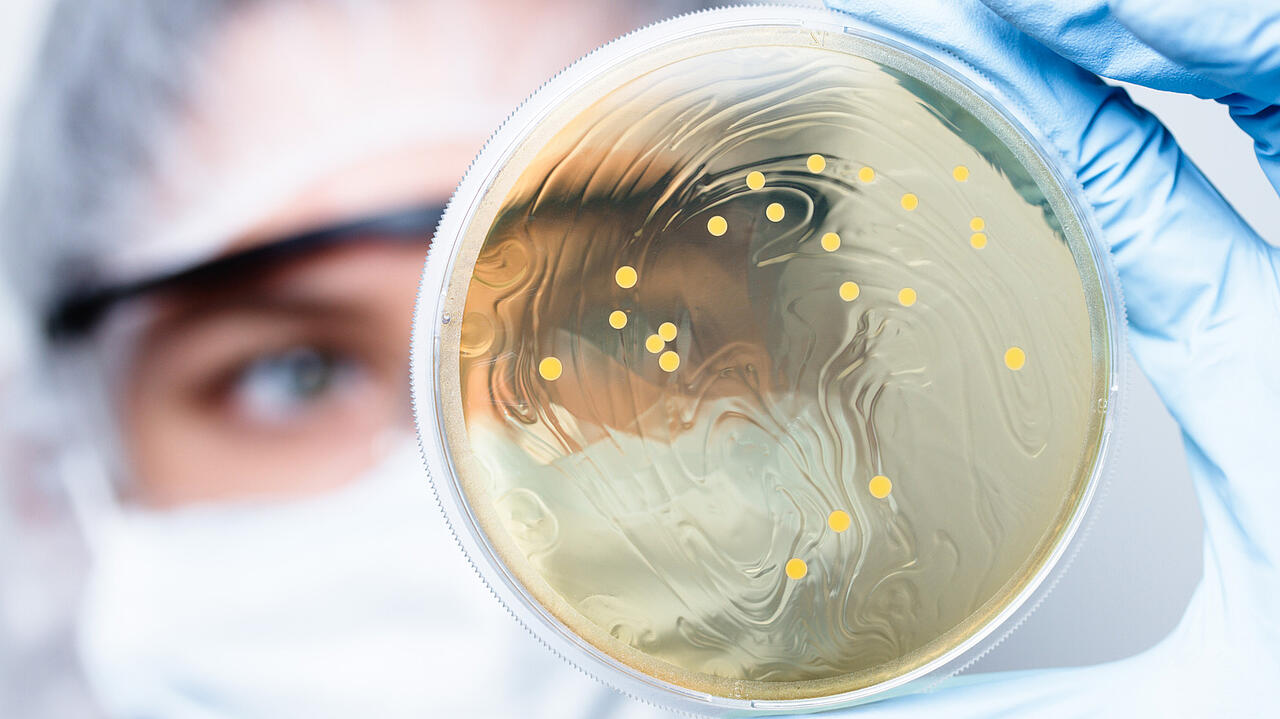
Forscher im Hintergrund mit Petrischale mit Bakterien in der Hand (Vordergrund)

Medical applications

Trust our core competence: innovative aerosol technologies
Do you work in the field of inhalation toxicology, investigate human influences on our wastewater system (ecotoxicology), develop occupational health and safety guidelines in accordance with the CLP Regulation (Classification, Labelling and Packaging of Chemicals) or carry out aerosol-based basic medical research?
As an aerosol physician, biochemist, pharmacist, or toxicologist, the starting point of your activity is our core competence: successfully active in the field of aerosol technologies for decades, we produce devices to generate the defined aerosols that you need for your studies and experiments. No matter what the starting material is – powder, liquid, solution or suspension (including microorganisms or viruses). The simulation of real processes by synthesising aerosols is our core business. The same applies to sampling, sample preparation and characterisation with sophisticated measurement technology, which you can obtain from us separately or in combination with the corresponding hardware. Together with a broad customer base that reflects the versatility of toxicological testing and the great potential of medical applications, our product range has grown along with it over the past three decades. See for yourself.
WE ARE NOT AFRAID OF YOUR TOXIC TESTS.
Topas technologies for in-vivo, in-vitro, and ex-vivo/situ research

The following products – developed and manufactured in Germany – are suitable for your purposes:
- preparation of suspensions or cell lysates (UDS 751 Ultrasonic Disintegrator)
- Fractionation of suspensions or powders (EMS 755 electromagnetic sieve vibrator)
- for dosing and dispersion powders (SAG series)
- for dispersion of liquids, solutions, suspensions and emulsions (ATM series)
- for drying aerosols (DDU 570 diffusion dryer)
- for the removal of volatile organic compounds (VOC) from air or aerosol streams (TDD 590 Thermodenuder)
- for setting defined particle concentrations (DIL series)
- for modifying the aerosol charge state (EAN 581)
- aerosol spectrometers (LAP series) for analysis of particle size distribution and particle concentration
- aerosol photometers (PAP series) for monitoring of particle mass concentrations
Our devices comply with nationally, regionally, and internationally approved standards (e.g.: ISO, EN, DIN, ANSI) and guidelines (including OECD, FDA, VDI).
Our technologies generate, condition and characterise aerosols. Toxicologists, occupational health and safety experts and scientists from industry, research and medical institutions, from governmental institutions at the federal and state levels, as well as from non-governmental organisations rely on our sophisticated equipment developed from customer needs, to perform a wide variety of investigations and tests, including those in the field of inhalation toxicology:
- air Liquid Interface (ALI) tests
- acute and chronic inhalation toxicity tests (OECD 403, OECD 413)
- medical applications, e.g., dose studies
- ecotoxicity tests
- substance characterisation for REACH
- simulation of different scenarios of human emissions
- calibration and validation of medical technology
Strong in medical applications with a proven history
The Topas range of devices was and is developed, designed and continuously improved together with researchers and based on specific customer requests. Since the company was founded, we have taken our inspiration from active developmental work: Topas stands not only for the highest technical and directive-compliant standards, but also for compact design, user-friendly operability and mobile application – points that you will appreciate in your daily work.